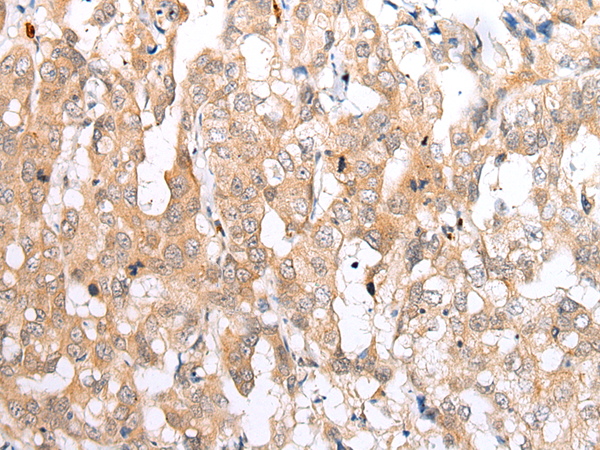
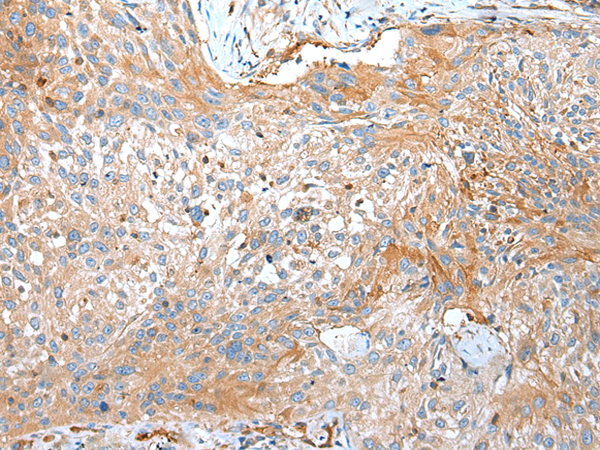
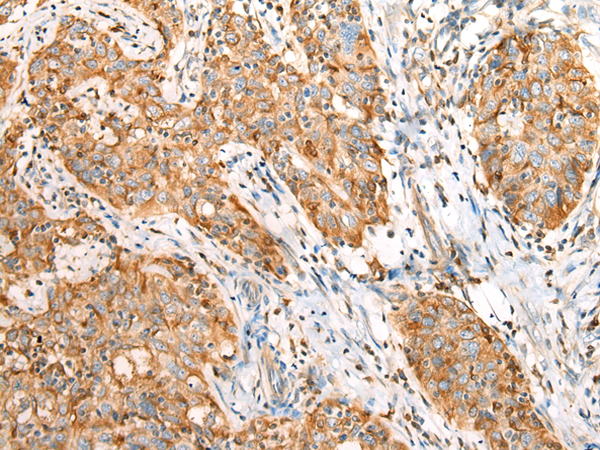

-
分类: 科研抗体货号: P12543别名: BAM; BIM; BOD应用: WB,IHC反应种属: Human, Mouse, Rat
-
分类: 科研抗体货号: P12534别名: BIP; BMP3B; BMP-3b应用: IHC反应种属: Human, Mouse, Rat
-
分类: 科研抗体货号: P12523别名: M6S1; NPP1; NPPS; PC-1; PCA1; ARHR2; COLED; PDNP1应用: IHC反应种属: Human
-
分类: 科研抗体货号: P12542别名: BAG-2; dJ417I1.2应用: WB,IHC反应种属: Human
-
分类: 科研抗体货号: P12533别名: CMTX; CX32; CMTX1应用: IHC反应种属: Human, Mouse, Rat
-
分类: 科研抗体货号: P12551别名: CAT1; CATL; ZFAB; ECAC2; ABP/ZF; LP6728; HSA277909应用: IHC反应种属: Human, Mouse, Rat
-
分类: 科研抗体货号: P12540别名: NAC; CARD7; CIDED; NALP1; SLEV1; DEFCAP; PP1044; VAMAS1; CLR17.1; DEFCAP-L/S应用: IHC反应种属: Human
-
分类: 科研抗体货号: P12532别名: GADD34应用: IHC反应种属: Human
-
分类: 科研抗体货号: P12549别名: C2orf2; ELP120; EMAP-4; EMAPL4; ROPP120应用: IHC反应种属: Human
-
分类: 科研抗体货号: P12538别名: COX8-3应用: IHC反应种属: Human

鄂公网安备42018502007531号
鄂公网安备42018502007531号

